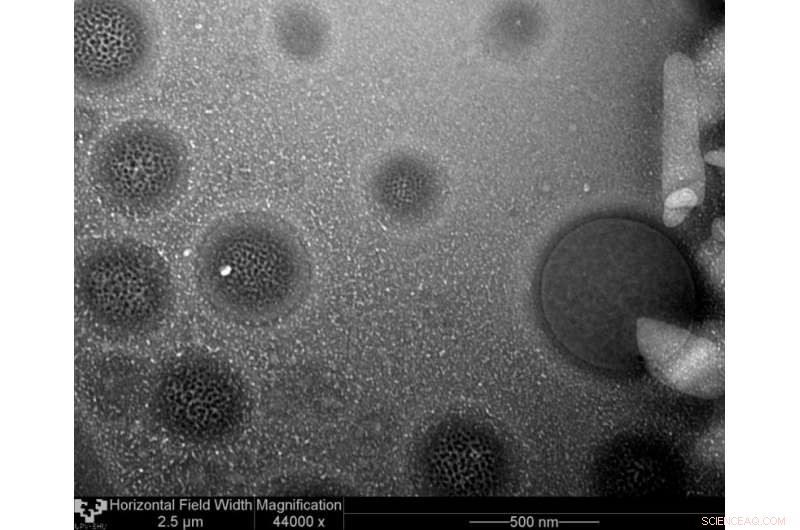
Advanced Lipid Nanoparticles: Revolutionizing Gene Therapy Delivery

Lipid nanoparticles. Credit: UPV/EHU
Lipid nanoparticles (SLNs and NLCs) are regarded as highly promising systems for delivering nucleic acids in gene therapy. Until now, viral systems have been the most effective method for delivering genetic matter but they pose significant safety problems. "Non-viral vectors, including SLNs and NLCs, are less effective but much safer even though their effectiveness has increased significantly in recent years," pointed out Alicia Rodríguez, María Ángeles Solinís and Ana del Pozo, authors of the article published in the European Journal of Pharmaceutics and Biopharmaceutics.
This review article describes these systems and their main advantages in gene therapy, such as their capacity to protect the gene material against degradation, to facilitate cell and nucleus internalisation and to boost the transfection process. "What is more, the nanoparticles are made up of biocompatible, biodegradable materials, they are easy to produce on a large scale, they can be sterilised and freeze-dried and are very stable both in biological fluids and in storage," explained the researchers.
This review also includes the main diseases in which lipid nanoparticles are being applied, generally on the preclinical level—degenerative diseases of the retina, infectious diseases, metabolic disorders, and cancer, among others. "At PharmaNanoGene we are working on the design and evaluation of SLNs for treating some of these diseases using gene therapy. We are studying the relationship between formulation factors and the processes involving the intracellular internalisation and disposition of the genetic material that condition the effectiveness of the vectors and which is essential in the optimisation process, and for the first time we have demonstrated the capacity of SLNs to induce the synthesis of a protein following their intravenous administration in mice," they stressed.
The publication also includes other pieces of work by this UPV/EHU research group on the application of SLNs in the treatment of rare diseases, such as chromosome-X-linked juvenile retinoschisis, a disorder in which the retina becomes destructured due to a deficiency in the protein retinoschisin. "One of the main achievements of our studies in this field has been to demonstrate, also for the first time, the capacity of a non-viral vector to transfect the retina of animals lacking the gene that encodes this protein and partially restore its structure, showing than non-viral gene therapy is a viable, promising therapeutic tool for treating degenerative disorders of the retina," specified the researchers.
The application of SLNs for treating Fabry disease, a serious, multi-system metabolic disorder of a hereditary nature, has also been studied at PharmaNanoGene. "This is a monogenic disease linked to the X-chromosome which is caused by various gene mutations in the gene that encodes the a-galactosidase A (a-Gal A) enzyme. In cell models of this disease we have demonstrated the capacity of SLNs to induce the synthesis of a-Gal A." They have also reviewed the application of lipid nanoparticles to the treatment of infectious diseases: "Our work in this field shows that SLNs with RNA interference are capable of inhibiting a replicon of the hepatitis C virus in vitro, which was used as proof-of-concept of the use of SLN-based vectors as a new therapeutic strategy for treating this infection and others related to it."